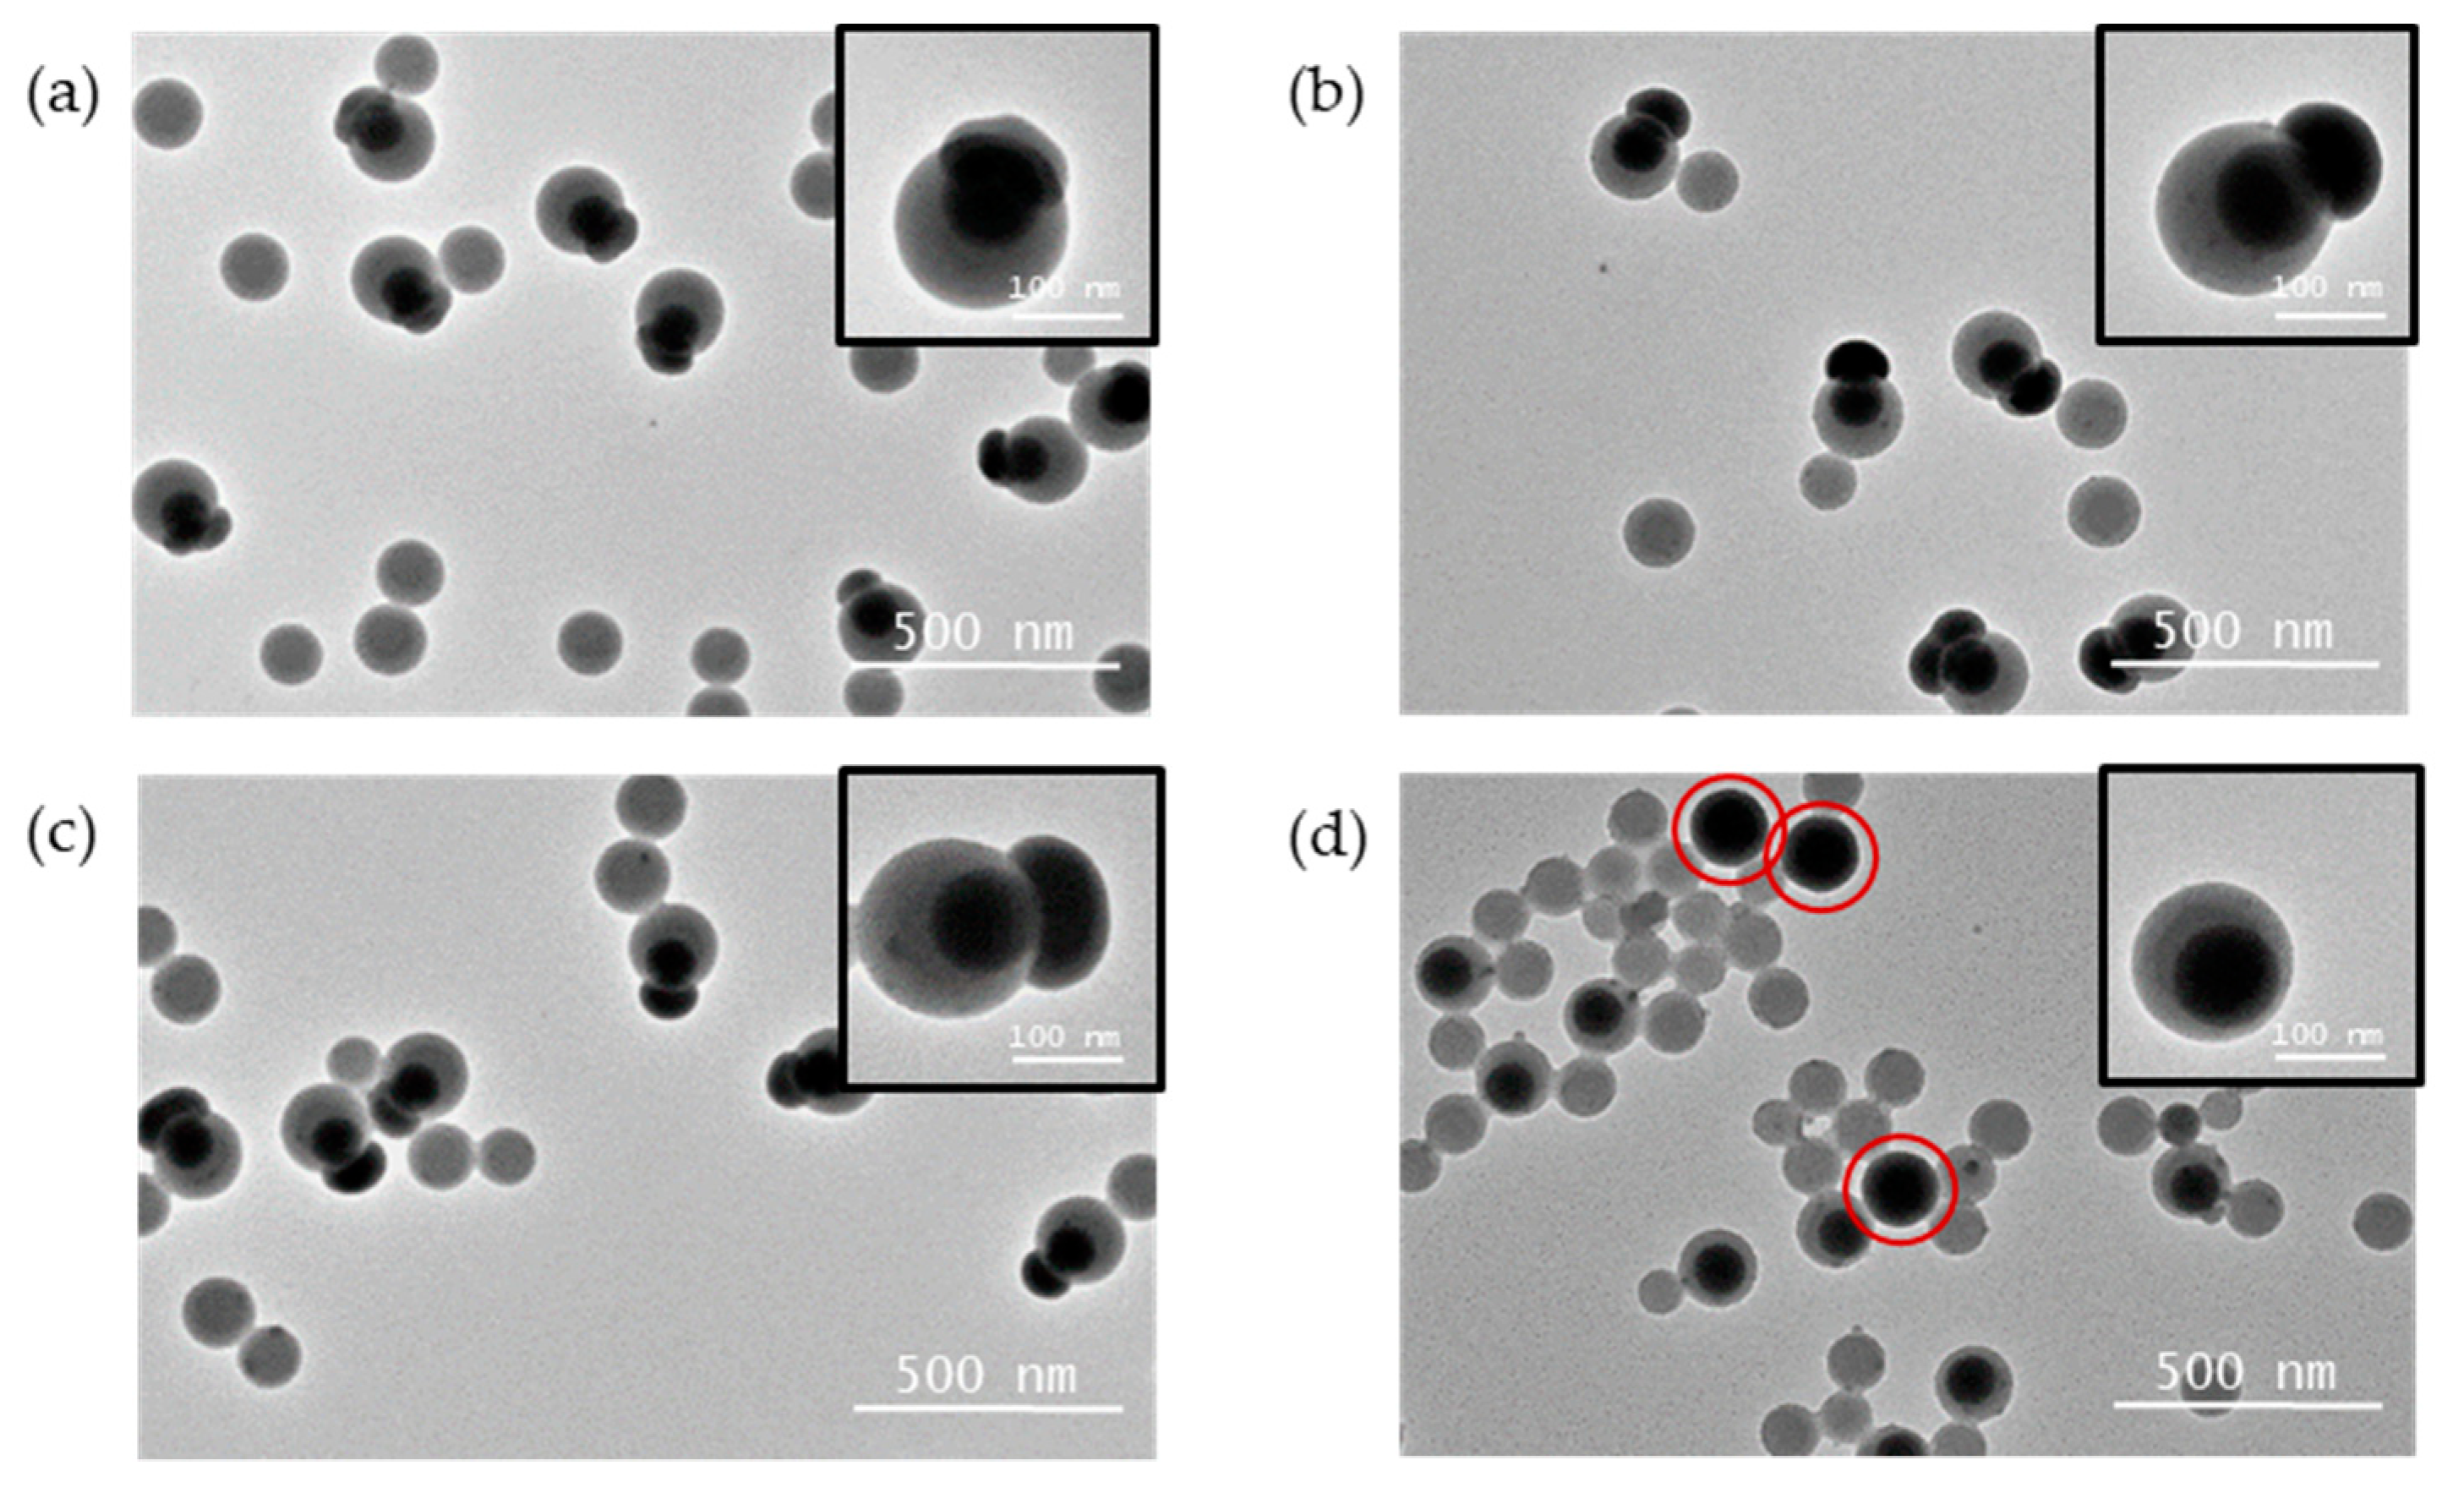

Towards Polymeric Nanoparticles with Multiple Magnetic Patches
Abstract
1. Introduction
2. Materials and Methods
2.1. Materials
2.2. Colloid Synthesis
2.3. Solvent-Induced Colloidal Self-Assembly
2.4. Characterization by Electron Microscopy
3. Results and Discussion
3.1. Preparation of Silica/Polystyrene Monopods
3.2. Solvent-Induced Self-Assembly of Silica/Polystyrene Monopods
3.3. Extending the Strategy to Magnetic Silica Patches
4. Conclusions
Supplementary Materials
Author Contributions
Funding
Institutional Review Board Statement
Informed Consent Statement
Data Availability Statement
Acknowledgments
Conflicts of Interest
References
- Boles, M.A.; Engel, M.; Talapin, D.V. Self-Assembly of Colloidal Nanocrystals: From Intricate Structures to Functional Materials. Chem. Rev. 2016, 116, 11220–11289. [Google Scholar] [CrossRef] [PubMed]
- Wu, N.; Lee, D.; Striolo, A. (Eds.) Anisotropic Particle Assemblies; Elsevier: Amsterdam, The Netherlands, 2018; ISBN 9780128040690. [Google Scholar]
- Zhang, Z.; Glotzer, S.C. Self-Assembly of Patchy Particles. Nano Lett. 2004, 4, 1407–1413. [Google Scholar] [CrossRef] [PubMed]
- Rodríguez-Fernández, D.; Liz-Marzán, L.M. Metallic Janus and Patchy Particles. Part. Part. Syst. Charact. 2013, 30, 46–60. [Google Scholar] [CrossRef]
- Yi, G.-R.; Pine, D.J.; Sacanna, S. Recent progress on patchy colloids and their self-assembly. J. Phys. Condens. Matter 2013, 25, 193101. [Google Scholar] [CrossRef] [PubMed]
- Van Anders, G.; Klotsa, D.; Karas, A.S.; Dodd, P.M.; Glotzer, S.C. Digital Alchemy for Materials Design: Colloids and Beyond. ACS Nano 2015, 9, 9542–9553. [Google Scholar] [CrossRef] [PubMed]
- Ravaine, S.; Duguet, E. Synthesis and assembly of patchy particles: Recent progress and future prospects. Curr. Opin. Colloid Interface Sci. 2017, 30, 45–53. [Google Scholar] [CrossRef]
- Li, W.; Palis, H.; Mérindol, R.; Majimel, J.; Ravaine, S.; Duguet, E. Colloidal molecules and patchy particles: Complementary concepts, synthesis and self-assembly. Chem. Soc. Rev. 2020, 49, 1955–1976. [Google Scholar] [CrossRef]
- Tierno, P. Recent advances in anisotropic magnetic colloids: Realization, assembly and applications. Phys. Chem. Chem. Phys. 2014, 16, 23515–23528. [Google Scholar] [CrossRef]
- Teo, B.M.; Young, D.J.; Loh, X.J. Magnetic Anisotropic Particles: Toward Remotely Actuated Applications. Part. Part. Syst. Charact. 2016, 33, 709–728. [Google Scholar] [CrossRef]
- Rossi, L. Magnetic Colloids as Building Blocks for Complex Structures: Preparation and Assembly. Front. Nanosci. 2019, 13, 1–22. [Google Scholar] [CrossRef]
- Walther, A.; Müller, A.H.E. Janus Particles: Synthesis, Self-Assembly, Physical Properties, and Applications. Chem. Rev. 2013, 113, 5194–5261. [Google Scholar] [CrossRef] [PubMed]
- Zhang, J.; Grzybowski, B.A.; Granick, S. Janus Particle Synthesis, Assembly, and Application. Langmuir 2017, 33, 6964–6977. [Google Scholar] [CrossRef] [PubMed]
- Ma, F.; Yang, X.; Wu, N. Directed assembly of anisotropic particles under external fields. In Anisotropic Particle Assemblies; Elsevier: Amsterdam, The Netherlands, 2018; pp. 131–165. ISBN 9780128040690. [Google Scholar]
- Yammine, E.; Souaid, E.; Youssef, S.; Abboud, M.; Mornet, S.; Nakhl, M.; Duguet, E. Particles with Magnetic Patches: Synthesis, Morphology Control, and Assembly. Part. Part. Syst. Charact. 2020, 37, 2000111. [Google Scholar] [CrossRef]
- Chen, C.-H.; Abate, A.R.; Lee, D.; Terentjev, E.M.; Weitz, D.A. Microfluidic Assembly of Magnetic Hydrogel Particles with Uniformly Anisotropic Structure. Adv. Mater. 2009, 21, 3201–3204. [Google Scholar] [CrossRef]
- Sacanna, S.; Rossi, L.; Pine, D.J. Magnetic Click Colloidal Assembly. J. Am. Chem. Soc. 2012, 134, 6112–6115. [Google Scholar] [CrossRef]
- Skelhon, T.S.; Chen, Y.; Bon, S.A.F. Hierarchical self-assembly of ‘hard–soft’ Janus particles into colloidal molecules and larger supracolloidal structures. Soft Matter 2014, 10, 7730–7735. [Google Scholar] [CrossRef]
- Ge, X.-H.; Geng, Y.-H.; Chen, J.; Xu, J.-H. Smart Amphiphilic Janus Microparticles: One-Step Synthesis and Self-Assembly. ChemPhysChem 2018, 19, 2009–2013. [Google Scholar] [CrossRef]
- Li, W.; Ravaine, S.; Duguet, E. Clustering of asymmetric dumbbell-shaped silica/polystyrene nanoparticles by solvent-induced self-assembly. J. Colloid Interface Sci. 2020, 560, 639–648. [Google Scholar] [CrossRef]
- Désert, A.; Chaduc, I.; Fouilloux, S.; Taveau, J.-C.; Lambert, O.; Lansalot, M.; Bourgeat-Lami, E.; Thill, A.; Spalla, O.; Ravaine, S.; et al. High-Yield preparation of polystyrene/silica clusters of controlled morphology. Polym. Chem. 2012, 3, 1130. [Google Scholar] [CrossRef]
- Paquet, C.; Pagé, L.; Kell, A.; Simard, B. Nanobeads Highly Loaded with Superparamagnetic Nanoparticles Prepared by Emulsification and Seeded-Emulsion Polymerization. Langmuir 2010, 26, 5388–5396. [Google Scholar] [CrossRef][Green Version]
- Massart, R. Preparation of aqueous magnetic liquids in alkaline and acidic media. IEEE Trans. Magn. 1981, 17, 1247–1248. [Google Scholar] [CrossRef]
- Van Ewijk, G.A.; Vroege, G.J.; Philipse, A.P. Convenient preparation methods for magnetic colloids. J. Magn. Magn. Mater. 1999, 201, 31–33. [Google Scholar] [CrossRef]
- Torquato, S.; Truskett, T.M.; Debenedetti, P.G. Is Random Close Packing of Spheres Well Defined? Phys. Rev. Lett. 2000, 84, 2064–2067. [Google Scholar] [CrossRef] [PubMed]
- Hubert, C.; Chomette, C.; Désert, A.; Sun, M.; Treguer-Delapierre, M.; Mornet, S.; Perro, A.; Duguet, E.; Ravaine, S. Synthesis of multivalent silica nanoparticles combining both enthalpic and entropic patchiness. Faraday Discuss. 2015, 181, 139–146. [Google Scholar] [CrossRef] [PubMed]
- Ge, J.; Hu, Y.; Zhang, T.; Yin, Y. Superparamagnetic Composite Colloids with Anisotropic Structures. J. Am. Chem. Soc. 2007, 129, 8974–8975. [Google Scholar] [CrossRef] [PubMed]
- Désert, A.; Hubert, C.; Fu, Z.; Moulet, L.; Majimel, J.; Barboteau, P.; Thill, A.; Lansalot, M.; Bourgeat-Lami, E.; Duguet, E.; et al. Synthesis and Site-Specific Functionalization of Tetravalent, Hexavalent, and Dodecavalent Silica Particles. Angewandte Chemie Int. Ed. 2013, 52, 11068–11072. [Google Scholar] [CrossRef]
- Désert, A.; Morele, J.; Taveau, J.-C.; Lambert, O.; Lansalot, M.; Bourgeat-Lami, E.; Thill, A.; Spalla, O.; Belloni, L.; Ravaine, S.; et al. Multipod-Like silica/polystyrene clusters. Nanoscale 2016, 8, 5454–5469. [Google Scholar] [CrossRef]
- Reculusa, S.; Poncet-Legrand, C.; Perro, A.; Duguet, E.; Bourgeat-Lami, E.; Mingotaud, C.; Ravaine, S. Hybrid Dissymmetrical Colloidal Particles. Chem. Mater. 2005, 17, 3338–3344. [Google Scholar] [CrossRef]
- Bourgeat-Lami, E.; Lang, J. Encapsulation of Inorganic Particles by Dispersion Polymerization in Polar Media. J. Colloid Interface Sci. 1998, 197, 293–308. [Google Scholar] [CrossRef]
- Corcos, F.; Bourgeat-Lami, E.; Novat, C.; Lang, J. Poly(styrene-b-ethylene oxide) copolymers as stabilizers for the synthesis of silica-polystyrene core-shell particles. Colloid Polym. Sci. 1999, 277, 1142–1151. [Google Scholar] [CrossRef]
- Thill, A.; Désert, A.; Fouilloux, S.; Taveau, J.-C.; Lambert, O.; Lansalot, M.; Bourgeat-Lami, E.; Spalla, O.; Belloni, L.; Ravaine, S.; et al. Spheres Growing on a Sphere: A Model to Predict the Morphology Yields of Colloidal Molecules Obtained through a Heterogeneous Nucleation Route. Langmuir 2012, 28, 11575–11583. [Google Scholar] [CrossRef] [PubMed]
- Wang, Y.; Wang, Y.; Breed, D.R.; Manoharan, V.N.; Feng, L.; Hollingsworth, A.D.; Weck, M.; Pine, D.J. Colloids with valence and specific directional bonding. Nature 2012, 491, 51–55. [Google Scholar] [CrossRef] [PubMed]
- Forge, D.; Gossuin, Y.; Roch, A.; Laurent, S.; Vander Elst, L.; Muller, R.N. Development of magnetic chromatography to sort polydisperse nanoparticles in ferrofluids. Contrast Media Mol. Imaging 2010, 5, 126–132. [Google Scholar] [CrossRef] [PubMed]

| Entry | dMPS (funct./nm2) | Monomer-to-Polymer Conversion (%) | Final Batch Composition (%) 1 | PS Nodule Diameter (nm) | |||||
|---|---|---|---|---|---|---|---|---|---|
| Monopods | Bipods | Tripods | Tetrapods | Multisilica 2 | Monopods | Free Particles | |||
| #1.1 | 0.3 | 95 | 17 | 38 | 32 | 11 | 2 | 210 | 128 |
| #1.2 | 0.5 | 88 | 63 | 29 | 6 | - | 2 | 214 | 126 |
| #1.3 | 0.6 | 63 | 99 | - | - | - | 1 | 165 | 98 |
| #1.4 | 0.7 | 60 | 98 | - | - | - | 2 | 163 | 94 |
| #1.5 | 1.0 | 64 | 99 | - | - | - | 1 | 127 | 82 |
| #1.6 | 2.0 | 70 | 99 | - | - | - | 1 | 145 | 113 |
| #1.7 | 0.6 | 88 | 97 | - | - | - | 3 | 220 | 151 |
| #1.8 | 0.6 | 68 | 98 | 1 | - | - | 1 | 148 | 102 |
| Entry. | Ethanol/THF Volume Ratio | Monopod Concentration | Final Distribution of the Number of Silica Patches (%) 1 | ||||
|---|---|---|---|---|---|---|---|
| N = 1 2 | N = 2 | N = 3 | N = 4 | N ≥ 5 | |||
| #2.1 | 50/50 | C | 100 | - | - | - | - |
| #2.2 | 40/60 | C | 100 | - | - | - | - |
| #2.3 | 30/70 | C | 91 | 7 | 2 | - | - |
| #2.4 | 20/80 | C | 80 | 17 | 3 | - | - |
| #2.5 | 10/90 | C | 76 | 13 | 4 | 1 | 6 |
| #2.6 | 20/80 | 2C | 77 | 19 | 3 | 1 | - |
| #2.7 | 20/80 | 4C | 38 | 35 | 17 | 5 | 5 |
| Entry | dMPS (funct./nm2) | Monomer-to-Polymer Conversion (%) | Final Batch Composition (%) 1 | |||||||
|---|---|---|---|---|---|---|---|---|---|---|
| Monopods | Bipods | Tripods | Tetrapods | Pentapods | Hexapods | Other Multipods | Multisilica 2 | |||
| #3.0 3 | 0.6 | 95 | 96 | - | - | - | - | - | - | 4 |
| #3.1 | 0.6 | 88 | 4 | 9 | 4 | 4 | 6 | 65 | 7 | 1 |
| #3.2 | 1.0 | 76 | 3 | 6 | 14 | 30 | 10 | 23 | 11 | 3 |
| #3.3 | 1.5 | 66 | 44 | 30 | 19 | 6 | - | - | - | 1 |
| #3.4 | 1.9 | 93 | 90 | 1 | - | - | - | - | - | 9 |
| #3.5 | 1.9 | 85 | 96 | - | - | - | - | - | - | 4 |
| #3.6 | 1.9 | 91 | 94 | 2 | - | - | - | - | - | 4 |
Publisher’s Note: MDPI stays neutral with regard to jurisdictional claims in published maps and institutional affiliations. |
© 2021 by the authors. Licensee MDPI, Basel, Switzerland. This article is an open access article distributed under the terms and conditions of the Creative Commons Attribution (CC BY) license (http://creativecommons.org/licenses/by/4.0/).
Share and Cite
Yammine, E.; Adumeau, L.; Abboud, M.; Mornet, S.; Nakhl, M.; Duguet, E. Towards Polymeric Nanoparticles with Multiple Magnetic Patches. Nanomaterials 2021, 11, 147. https://doi.org/10.3390/nano11010147
Yammine E, Adumeau L, Abboud M, Mornet S, Nakhl M, Duguet E. Towards Polymeric Nanoparticles with Multiple Magnetic Patches. Nanomaterials. 2021; 11(1):147. https://doi.org/10.3390/nano11010147
Chicago/Turabian StyleYammine, Elham, Laurent Adumeau, Maher Abboud, Stéphane Mornet, Michel Nakhl, and Etienne Duguet. 2021. "Towards Polymeric Nanoparticles with Multiple Magnetic Patches" Nanomaterials 11, no. 1: 147. https://doi.org/10.3390/nano11010147
APA StyleYammine, E., Adumeau, L., Abboud, M., Mornet, S., Nakhl, M., & Duguet, E. (2021). Towards Polymeric Nanoparticles with Multiple Magnetic Patches. Nanomaterials, 11(1), 147. https://doi.org/10.3390/nano11010147

